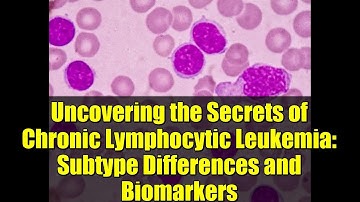
Uncovering the Secrets of Chronic Lymphocytic Leukemia: Subtype Differences and Biomarkers

⬇ DOWNLOAD NOW
Kalau muncul iklan pop-up, tutup lalu klik tombol kembali
Download lagu Unveiling the Differences Between CLL Subtypes: New Insights & Biomarkers secara gratis hanya untuk keperluan promosi. Dukung artis favorit kamu dengan membeli musik original di iTunes atau platform resmi lainnya.
Uncovering the Secrets of Chronic Lymphocytic Leukemia: Subtype Differences and Biomarkers
Uncovering the Secrets of Chronic Lymphocytic Leukemia: Subtype Differences and Biomarkers
 Identifying novel biomarkers and advancing the classification system in CLL
Identifying novel biomarkers and advancing the classification system in CLL
 Chronic Lymphocytic Leukemia Biomarkers
Chronic Lymphocytic Leukemia Biomarkers
 A real-world analysis of CNS involvement in CLL
A real-world analysis of CNS involvement in CLL
 The evolution of treatment patterns and prognostic biomarkers in Latin American CLL patients
The evolution of treatment patterns and prognostic biomarkers in Latin American CLL patients
 Leukemia Genetics and Biomarkers
Leukemia Genetics and Biomarkers
 Understanding Chronic Lymphocytic Leukemia/Small Lymphocytic Lymphoma
Understanding Chronic Lymphocytic Leukemia/Small Lymphocytic Lymphoma
 Defining high-risk disease in CLL
Defining high-risk disease in CLL